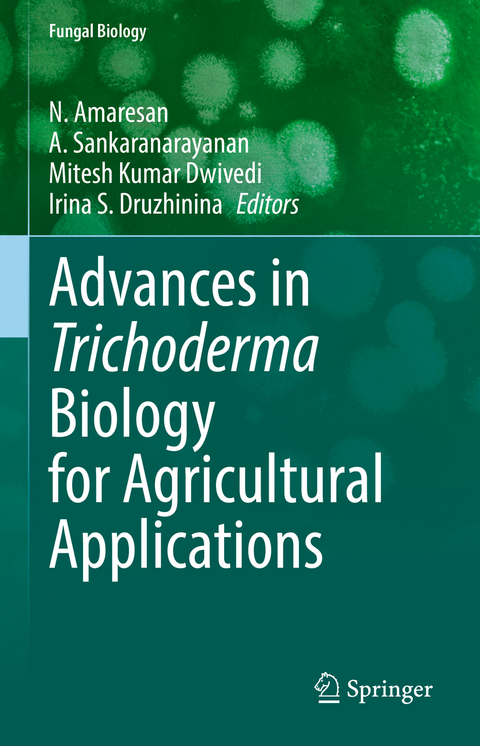
Advances in Trichoderma Biology for Agricultural Applications -

Advances in Trichoderma Biology for Agricultural Applications
Springer International Publishing (Verlag)
978-3-030-91649-7 (ISBN)
Reading this book should kindle further discussions among researchers working in fungal biotechnology, microbiology, agriculture, environmental science, forestry, and other allied subjects and thus lead to a broader scope of Trichoderma-based products and technologies. The knowledge shared in this book should also provide a warning on the potential risks associated with Trichoderma.
Dr. N. Amaresan is an Assistant Professor at C.G. Bhakta Institute of Biotechnology, Uka Tarsadia University, Gujarat. He has over fifteen years of experience in teaching & research in various allied fields of microbiology mainly plant-microbe interactions, bioremediation, plant pathology and others. He has been awarded young scientist awards by Association of Microbiologists of India and National Academy of Biological Sciences. He also been awarded visiting scientist fellowship from National Academy of India to learn advanced techniques. He has published more than 100 research articles, book chapters and books of national and international reputes. He also deposited over 550 16S rDNA, 28S rDNA and ITS rDNA sequences in the Genbank (NCBI, EMBL & DDBJ) and also preserved over 150 microbial germplasm in various culture collection centres of India. He has successfully completed research projects from national funding agencies such as SERB-DST, GUJCOST, UTU, & GEMI and guided students for their doctoral and master degrees.
Dr. A. Sankaranarayanan is an Associate Professor in Life Sciences, Sri Sathya Sai University for Human Excellence, Kalaburagi of Karnataka state, India from June 2021 onwards. His current research focus is on fermented food products. He has published 30 chapters in books, 60 research articles in International and National journals of repute, guided 5 Ph.D., and 16 M.Phil., scholars and operated 5 minor funded projects in Microbiology. From 2002 -2015, he worked as an Assistant Professor & Head, Department of Microbiology, K.S.R. College of Arts & Science, Tiruchengode, Tamil Nadu and August, 2015- May, 2021 associated with Uka Tarsadia University, Surat of Gujarat state, India. He has awarded with Indian Academy of Sciences (IASc), National Academy of Sciences (NAS) and The National Academy of Sciences (TNAS) sponsored summer research fellowship for young teachers consecutively for three years and name is included as a Mentor in DST-Mentors/Resource persons for summer/winter camps and other INSPIRE initiatives, Department of Science & Technology, Govt. of India, New Delhi. He is a Grant reviewer in British Society of Antimicrobial Chemotherapy (BSAC), UK.
Dr. Mitesh Kumar Dwivedi is an Assistant Professor of Microbiology at C. G. Bhakta Institute of Biotechnology, Uka Tarsadia University. He has published 51 research papers in reputed journals, written 14 book chapters and is editor of 6 books. He has h-index of 21 with 1521 citations for his research papers. He has more than 13 years of experience in research & teaching in various allied fields of microbiology & life science including host-microbe interaction, probiotics, herbal medicine, immunobiology and others. He has been serving as an editorial board member and reviewer of many international journals. He has been honoured with international as well as national awards for excellent research performance [Best Researcher Award (2020), INSA Visiting Scientist Award (2019), DST-SERB Early Career Research Award (2018), Young Scientist Awards (2011, 2013 & 2018)]. He secured All India rank '32' in CSIR-NET national examination (2011; Life Sciences). He has successfully completed research projects from national funding agencies such as SERB-DST, GUJCOST, UTU, Neosciences & Research Solutions Pvt. Ltd. and guided students for their doctoral and master degrees.
Dr. Irina S. Druzhinina is a professor of Microbiology in the College of Resources and Environmental Sciences in Nanjing Agricultural University (China), head of the International Committee on Trichoderma Taxonomy, member of the International Committee of Taxonomy of Fungi, IUMS, and an editor of the Applied and Environmental Microbiology (AEM) journal (ASM). Before moving to China in 2019, for many years, Irina ran the group of Microbiology and Applied Genomics in TU Wien (Vienna, Austria), where she studied fungal DNA Barcoding and
The current state of Trichoderma taxonomy and species identification.- Functional genetics of Trichoderma mycoparasitism.- Trichoderma secondary metabolites involved in microbial inhibition.- Genes involved in the secondary metabolism of Trichoderma and the biochemistry of these compounds.- New insights on the duality of Trichoderma as a phytopathogen killer and a plant protector, based on integrated multi-omics perspective.- The role of secondary metabolites in rizosphere competence of Trichoderma.- Elicitor proteins from Trichoderma for biocontrol potentials.- Genus Trichoderma: Its role in induced systemic resistance of plants against phytopathogens.- Role of Trichoderma in Plant Growth Promotion.- Metabolomic approaches to study Trichoderma-plant interactions.- Management of salinity stress by the application of Trichoderma.- Tolerance to and alleviation of abiotic stresses in plants mediated by Trichoderma spp.- Trichoderma genes for abiotic stress tolerance in plants.- Development, production, and storage of Trichoderma formulations for agricultural applications.- Regulatory issues in commercialization of Trichoderma-based products in the USA.- Industrially important genes from Trichoderma.- Biosynthesis of metal-based nanoparticles by Trichoderma and its potential applications.- Trichoderma role in anthropogenic pollutions mycoremediation: pesticides and heavy metals.- Trichoderma and its products from laboratory to patient bedside in medical Science -an emerging aspect.- Trichoderma enzymes in wine and beer industry.- Trichoderma green mould disease of cultivated mushrooms.- Trichodermosis: Human infections caused by Trichoderma species.
| Erscheinungsdatum | 13.06.2022 |
|---|---|
| Reihe/Serie | Fungal Biology |
| Zusatzinfo | XIV, 650 p. 76 illus., 60 illus. in color. |
| Verlagsort | Cham |
| Sprache | englisch |
| Maße | 155 x 235 mm |
| Gewicht | 1088 g |
| Themenwelt | Naturwissenschaften ► Biologie ► Genetik / Molekularbiologie |
| Naturwissenschaften ► Biologie ► Mikrobiologie / Immunologie | |
| Naturwissenschaften ► Biologie ► Mykologie | |
| Schlagworte | biocontrol • Mycoparasitism • opportunistic infection • Plant growth promotion • Trichoderma |
| ISBN-10 | 3-030-91649-9 / 3030916499 |
| ISBN-13 | 978-3-030-91649-7 / 9783030916497 |
| Zustand | Neuware |
| Informationen gemäß Produktsicherheitsverordnung (GPSR) | |
| Haben Sie eine Frage zum Produkt? |
aus dem Bereich


